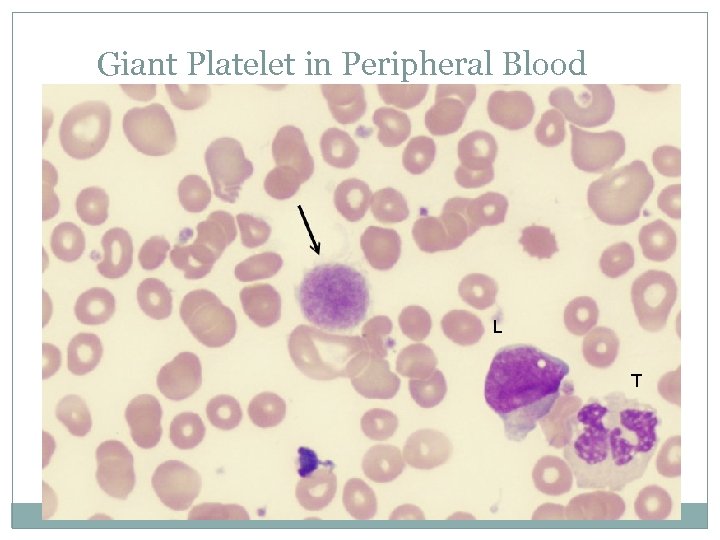
Giant Platelet in Peripheral Blood L T
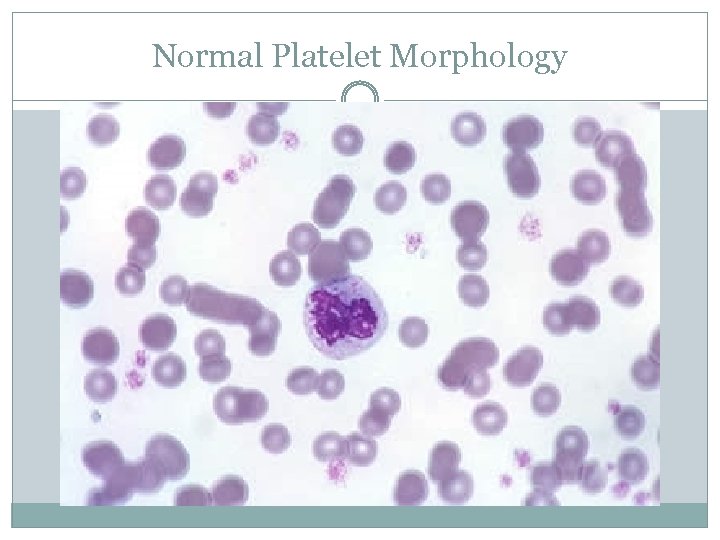
Normal Platelet Morphology
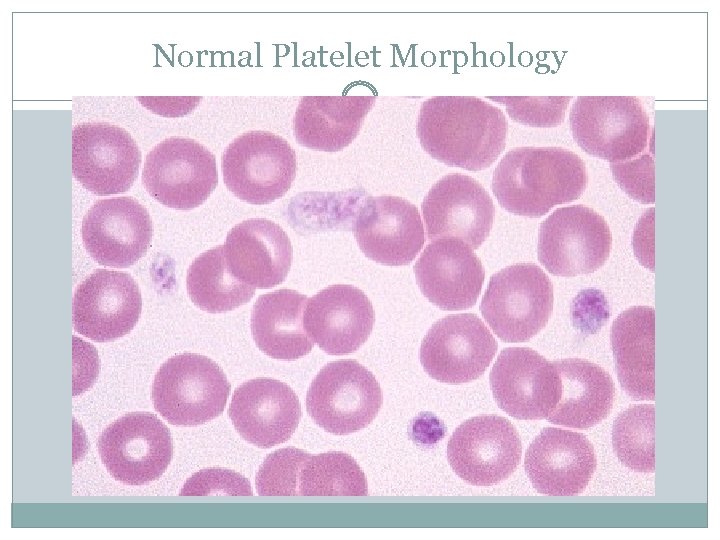
Normal Platelet Morphology
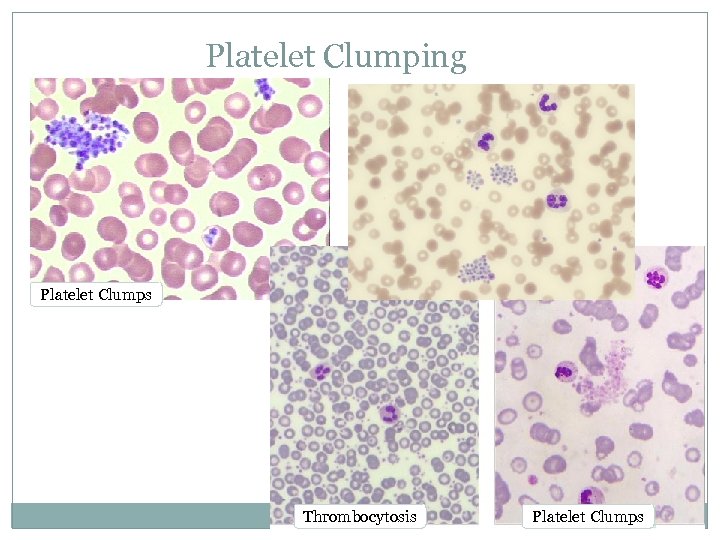
Platelet Clumping Platelet Clumps Thrombocytosis Platelet Clumps

7a7bbe9585308ec6c4f0e304487e9c4d.ppt
- Количество слайдов: 66

Thrombocytes and Coagulation VTHT 2323 CLINICAL PATHOLOGY KRISTIN CANGA, RVT

Reading Assignment A&P: PG. 230 LAB PRO: PP. 30 -32 (ANTICOAGULANTS) AND 69 -73

Thrombocyte Formation Production of platelets = ______________ Produced in bone marrow by _____________(TPO) = stimuli for PPSCs to differentiate into thrombocyte precursor. Platelet parent cell = _________________

Thrombocyte Formation Megakaryocyte undergoes incomplete ______: (__________ divides but cytoplasm doesn’t) Small chunks (~1, 000 – 5, 000 per megakaryocyte) break off while still in bone marrow, and are sent into circulation as platelets Some platelets are stored in _______ for release as needed

Megakaryocytes

Megakaryocyte

Megakaryocytes

Megakaryocytes: Platelet formation Infoldings develop into plasma membrane that divide marginal ________ into little compartments. These compartments break off and enter bloodstream as _______. Some platelets are stored in the ______, while others circulate freely in the blood and live for about ____ days in dogs and just over ___ day in cats.

Megakaryocyte Video http: //www. youtube. com/watch? v=6 R- ESPFi. Kbo&feature=related&ajax=1&nocache=12710 11451258

Thrombocytes Commonly referred to as ________. Not complete cells (lack a ______), but frequently listed as one of the cell types in peripheral blood. RBCs>PLTs>WBCs Have a greater variety of _________than any of the true blood cells. Are responsible for _________phase of clot formation AND initiation of ________phase of clot formation.

Thrombocyte Morphology Most are ________than RBCs Most PLTs in circulation are _______ and have numerous, small, purple/pink _______ scattered throughout the cytoplasm. Occasionally _____ platelets are seen in blood smear Giant platelets are considered more ________ than smaller platelets
Giant Platelet in Peripheral Blood L T

Platelets… Play a part in both the _________ and _________ formation of clots. Secrete ____________ Form platelet plugs Secrete __________ Initiate dissolution of blood clots (“____________”) Secrete ________that attract neutrophils and monocytes to sites of inflammation Secrete _______ factors to help maintain and repair blood vessels

Normal Platelet Values Canine: 200, 000 – 500, 000 /µL Feline: 300, 000 – 700, 000 /µL All species: ______ of ______/µL Horses = ______normal concentrations Cattle = ______normal concentrations Animals will bleed spontaneously if PLT concentration is ≤ ______ to ______ /µL
Normal Platelet Morphology
Normal Platelet Morphology

Function of Platelets are essential for ________. Role of platelets depends on _______ numbers being present in the blood. There are 3 main functions of platelets: 1) Maintenance of _________ integrity 2) _____________ formation 3) ___________ of plug by contributing to _______ formation.

Function of Platelets: 1) Vascular Integrity Platelets attach to ____________ Release endothelial ______ factor into endothelial cells. (Prevents leakage of blood in to tissues) ________ or ________may occur if there are _________ numbers of platelets in circulation.

Platelets: 2) Plug Formation Damaged blood vessel initiates the _________ process of clot formation. Platelet _________ The platelets adhere _______ to the damaged vessel AND each other. _____ often affects this step in the clotting process Change shape and form _______ Allows platelets to intertwine with each other to create platelet _________. Platelet ___________ The intertwining of platelets to help stop bleeding and causes the release of _________ factors. Initiates the _________ Function of Platelets

Platelets: 2) Plug Formation, cont’d Release of platelet factors (PFs) that are necessary for the clotting process to be complete. The aggregation of platelets ________ the release of PFs Platelet ________ occurs after aggregation of platelets. This is the beginning of the ________ phase of clot formation.

Platelet Activation Platelets become activated when there is _______ to the lining of a blood vessel The platelets are attracted to the damaged area and stick to it. Once the platelet has stuck to the damaged vessel, it becomes activated. Activated platelets have a ______-like appearance and form _____“tails” as they try and catch other platelets. Dendritic “tails” are sometimes referred to as _____________

Activated Platelets

Normal Activated Platelets that have been slightly activated in the sample or by contact with the glass slide (as is common in feline samples) have a stellate form with dendritic processes ("a" in figure). The inset shows a large platelet with centrally aggregated granules which resemble a nucleus.
Platelet Clumping Platelet Clumps Thrombocytosis Platelet Clumps

Platelet Function: 3) Stabilization of Platelet Plug Often referred to as the “______ Matrix” or “Clotting _____” Each step must happen in _____ and ________ in order for the next step to occur. “______ Reaction” Converts soluble _______ to insoluble _____ strands among platelets. Acts as “scaffolding” to encourage ______.

Fun Video Introduction to Coagulation http: //www. youtube. com/watch? v=9 QVTHDM 90 io

Hemostasis is the process by which blood is prevented from leaking out of _______ blood vessels. Depends on three factors: _______ of blood vessels Presence of adequate __________ factors Adequate number of normal circulating _______ is a key player!!! 1. 2. Manufactures most clotting factors Bile = essential for _______ of vitamin ___

Stages of Coagulation _______ Hemostasis _____________ Primary ________ plug formation Platelet ________________ Does adhesion or aggregation CAUSE platelet activation?

Stages of Coagulation _________ Hemostasis _________ Cascade Ultimate goal = _____ for stabilization of platelet plug Involves three pathways to clotting: __________________ Pathway, and _________ Pathway

Stages of Coagulation Tertiary Hemostasis (________) _____ retraction – occurs after ~___ minutes Platelet Derived _______ Factor (PDGF) is secreted during clot retraction. _______ damage to all tissues involved Tissue __________ Activator is secreted Clot initiates its own __________.


Coagulation Simplified Extrinsic Clotting Mechanism • chemical outside of blood triggers blood coagulation • triggered by thromboplastin (not found in blood) • triggered when blood contacts damaged tissue Intrinsic Clotting Mechanism • chemical inside blood triggers blood coagulation • triggered by Hageman factor (found inside blood) • Triggered when blood contacts foreign surface

The Coagulation Cascade

Automated Hemostasis Testing Samples should be collected very carefully with minimal ________ damage. ______ collect sample through indwelling catheters. Can cause ______ or blow the vein through manipulation. Anticoagulant of choice = Sodium citrate Blocks calcium (but not as strongly as EDTA) Blue top tube (a. k. a – turquoise) Results of some testing may be affected by stress, illness, recent exercise, heat cycle (females)

Clotting Tests Assess one or more of the phases of ________ (primary, secondary or tertiary) Tests involving _______ hemostasis assess intrinsic, extrinsic and/or common pathways. All patients should undergo coagulation testing prior to undergoing a _________ procedure. Platelet estimation Buccal mucosal bleeding time Activated clotting time (ACT) Prothrombin time (PT) Partial thromboplastin time (PTT) Fibrinogen assay

Platelet Counting Methods ______ or ________ (least accurate) Most inaccuracies attributable to ________, giant platelets, RBC _______ Always use ______ sample to minimize error Manual methods: 1. Platelet estimation during blood film analysis 2. Formula? ALWAYS USE HIGH POWER, ____________ Unopette system & hemocytometer (NOT COMMONLY USED)

Buccal Mucosal Bleeding Time Tests _______ hemostasis Evaluates platelet _____ & _______(thrombocytopathy, thrombocytopenia) Evaluates endothelial cell function (_____) Test can be affected by certain __________

BMBT Procedure 1. 2. 3. 4. 5. 6. Place ________ animal in _______ recumbency. Use a strip of gauze to tie upper lip back and expose mucosal surface. (Also acts as _______) Using a Surgicutt® or a Simplate® lancet, create a small wound (~1 mm deep) Remove blood with filter paper at 30 -second intervals DO NOT TOUCH SKIN Stop timing when there is no more blood. Normal = ____ minutes (canine/feline)

Buccal mucosal bleeding time

Toenail Bleeding Time An alternative to BMBT Clip toenail just past quick to cause bleeding Keeping animal undisturbed, monitor for bleeding to cease Normal = <5 minutes (canine/feline)

Activated Clotting Time (ACT) Evaluates _________ hemostasis (all factors except Factor VII) Requires Vacutainer containing sterile ___________ earth to activate coagulation pathways 2 m. L of blood is collected directly into tube It is important that tube is pre-warmed and kept at 37º C. Test can be affected by significantly ______ platelet numbers Normal = ___ – ___seconds (canine/feline)

Prothrombin Time (PT) Evaluates adequacy of factors associated with ________ and ______ pathways Routinely done by ______ Factor XIII activity not evaluated Platelet substitute added to sample (thrombocytopenia does not interfere) Normal: Canine = 6. 4 - 7. 4 seconds; Feline = 7 - 11. 5 seconds

Partial Thromboplastin Time (PTT) Evaluates adequacy of factors associated with the ______ and ______ pathways Routinely done by machine Factor XIII activity not evaluated Platelet substitute added Normal: Canine = 9 -11 seconds; Feline = 10 -15 seconds

Fibrinogen Assay Can be done by ______ or ________ methods Only evaluates _________ concentration Can use ______ anticoagulated sample Concentrations may be increased during _________ or decreased when consumed during coagulation (_____) Normal: Canine = 100 – 250 mg/d. L Feline = 100 – 350 mg/d. L

Other Coagulation Tests Whole Blood Clotting time Clot Retraction Test One-Stage Prothrombin Time (OSPT) Used to confirm warfarin toxicity (rodenticide) Activated Partial Thromboplastin Time (APTT) PIVKA (proteins induced/invoked by vitamin K absence) d-Dimer and Fibrin Degradation Products

Quick Coagulation Testing

Coagulopathy Coagulation defects can be categorized as: Coagulation defects of primary hemostasis Coagulation defects of secondary hemostasis Defects of fibronolysis (tertiary hemostasis)

Coagulation Defects of Primary Hemostasis Coagulation defects of primary hemostasis ____________ or __________ (Quantity or quality) ________ bleeding Petechiae, mucosal bleeding, ecchymoses, epistaxis, melena, prolonged bleeding

Coagulation Defects of Primary Hemostasis ______________ Decreased _______ number Can be _________ or _________ #1 cause = infectious disease Ehrlichia, rickettsial diseases, babesiosis, systemic mycoses, toxoplasmosis, mycoplasmosis, Feline retroviruses (Fe. LV, FIP), others Other causes = bone marrow depression; unknown _______________ (v. Wd) Decreased or deficient v. WF= decreased PLT _______ , aggregation, and fibrin cross linking Can occur secondary to ___________ CS: MM hemorrhage, hematuria, GI bleeding, epistaxis Screening test of choice = _______

Defects of Secondary Hemostasis Coagulation defects of secondary hemostasis _______(e. g. pleural, peritoneal, retroperitoneal) _________formation Delayed bleeding/re-bleeding

Coagulation Defects of Secondary Hemostasis Congenital clotting factor deficiencies of virtually all known factors have been described. (e. g. : Hemophilia A & B) _______ coagulation defects can result from: #1 = ________ toxicity Inhibits vitamin K Vitamin K is required to activate factors II, VII, IX, and X One-step prothrombin time = test to confirm _______ toxicity. Liver disease, infiltrative bowel disease, and biliary obstruction can also inhibit Vitamin K

Disseminated Intravascular Coagulopathy (DIC) Not a disease in itself; it is a complex _________ that results from a pathologic condition. Involves _________ activation of platelets, coagulation proteins, and plasmin; evolving into consumption of coagulation proteins, platelets, and inhibitors of fibrinolysis Some of the many pathologic conditions associated with initiation of DIC include: Trauma and burns Metabolic acidosis/severe shock A large number of infectious diseases _____________ Systemic infection ____________ disease _____________ Sometimes considered an “________ ” condition

DIC Laboratory findings are highly _________ Classically ACT, PT, and thrombin time are prolonged; fibrinogen and platelet counts are decreased _____________ seen on smear Diagnosis is based on clinical suspicion and at least 3 abnormal coagulation test results. Clinical signs depend on the phase in which the patient is experiencing _______/Subacute phase: may have few to no overt clinical signs ______ (consumptive) phase: characterized by venipuncture oozing or modest to severe hemorrhage with inability to form a normal clot _______ phase: charactized by no clinical signs or oozing of blood Death is caused by extensive microthrombosis or circulatory failure, leading to single or multiple organ failure

Treatment of DIC Successful treatment depends on early detection in critically ill animals. Involves: CORRECTING UNDERLYING ___________ Support of target organs where microthrombi may cause hemorrhage Coagulation factor _________therapy Administration of ________ as needed (controversial) Fluid therapy – balanced electrolyte solutions to maintain effective circulating volume Should be accompanied by administration of _______ Close monitoring of antithrombin activity Prognosis is usually _______; depends on underlying cause If an animal survives an acute DIC event, a ______ form of DIC can exist

Other Acquired Coagulation Defects of Secondary Hemostasis _________ Disease The _____ synthesizes many of the clotting factors including factors I, II, V, VIII, IX, X, XI, and XII Liver manufacturers _____ which is essential in absorption of vitamin ___ from diet Disseminated Intravascular Coagulation (DIC) A complex syndrome with systemically accelerated coagulation It is clinically difficult to differentiate between hepatic disease and DIC because PT and PTT are usually prolonged with both. DIC can occur secondary to hepatic disease.

Qualitative Platelet Dysfunction Thrombocytopathia Most common cause is inappropriate use of ________. Can also be caused by: ________________ disorders Rare ___________ problems Certain ________

Thrombocytopathy: Drugs Causing Platelet Dysfunction Table 10 -3. Drugs Affecting Platelet Function Anesthetics General – Halothane Local - Procain Antibiotics Cephalosporins – Cefazolin Penicillins - Ampicillin Anticoagulants Heparin Antihistamines Chlorpheniramine Cardiovascular drugs Propanolol, Verapamil Foods and food additives Ethanol, onions Non-steroidal anti-inflammatory drugs Aspirin, Phenylbutazone Oncologic drugs Daunorubicin Plasma Expanders Heta. Starch, Dextrans Miscellaneous drugs Chlorpromazine

Tertiary Hemostatic Dysfunctions (Defective Fibrinolysis) The most common dysfunctional state is excessive ___________. This is an uncommon disease. Fibrinolysis _______ can also cause thrombus formation (a condition, not a disease state)

Other Bleeding Disorders Bleeding disorders may be caused by _______ or _______ defects in coagulation proteins, platelets, or vasculature. Inherited coagulation defects are usually associated with a _____ coagulation protein and often occur at a ______age. Acquired coagulation defects often affect ________ coagulation proteins and can occur at _____ age.

Anticoagulants and Hemostasis As you already know, anticoagulants _______ or ______ the formation of a clot. Anticoagulants are an important part of blood collection. Different anticoagulants are utilized depending on the _______ that are needed. On the following slides, we are going to talk about each anticoagulant and how it can affect your sample.

Heparin is acceptable for most tests requiring ________. (Green top) Heparinized tubes should be used for ________ chemistry analyzers. Heparin acts on the clotting cascade by preventing the conversion of _________ to ______ during the clotting process. Heparin also may cause _______of WBCs Heparin interferes with the ________ of WBCs and should not be used for blood films.

Ethylenediamine Tetraacetic Acid Commonly referred to as ______ (Purple top) Preferred anticoagulant for blood films because it does not alter cell ____________. Prevents clotting by binding with ________ , which is necessary for clot formation. Should not be used for ______ analysis because it affects the metabolism of certain chemicals in the blood and may __________ increase or decrease those chemicals. _______ EDTA can cause shrinkage of _____ This will invalidate automated chemistry machines.

Oxalates Available as: _____oxalate, ______________ oxalate, or _______oxalate. ___________ oxalate is most commonly used. (Grey top) Prevents clotting by binding with _____, which is necessary for clot formation. Not frequently used as it interferes with potassium tests, alkaline phosphatase tests, and lactate tests.

Citrates Available as: _______citrate, or _________citrate. Blue top Commonly used in ________ medicine Prevents clotting by binding with calcium, which is necessary for clot formation. Interfere with ______tests and many of the tests performed by ________ chemistry analyzers.

Sodium Flouride Known as _____ preservative but does have anticoagulant properties Prevents clotting by binding with calcium, which is necessary for clot formation. May be added to other samples that already have an ___________. Also _____top! Interferes with many ________ tests performed by automated analyzer.

Commonly Used Anticoagulants Table 2 -2 Name Mode of Action Advantages Disadvantages Uses Heparin Antithrombin Reversible, nontoxic Clumps WBCs, expensive, staining interference Critical RBC measurements EDTA Chelates calcium Best preservative Irreversible, shrinks cells Hematology Oxalates (potassium, Na, lithium) Chelates calcium Temporary Variable effects Coagulation Citrates (Na, lithium Chelates calcium Nontoxic, reversible Interferes with blood chemistry Transfusions, coagulation Fluorides (Na) Chelates calcium Inhibits cell metabolism Interferes w/ enzymatic tests Preserves blood glucose
7a7bbe9585308ec6c4f0e304487e9c4d.ppt